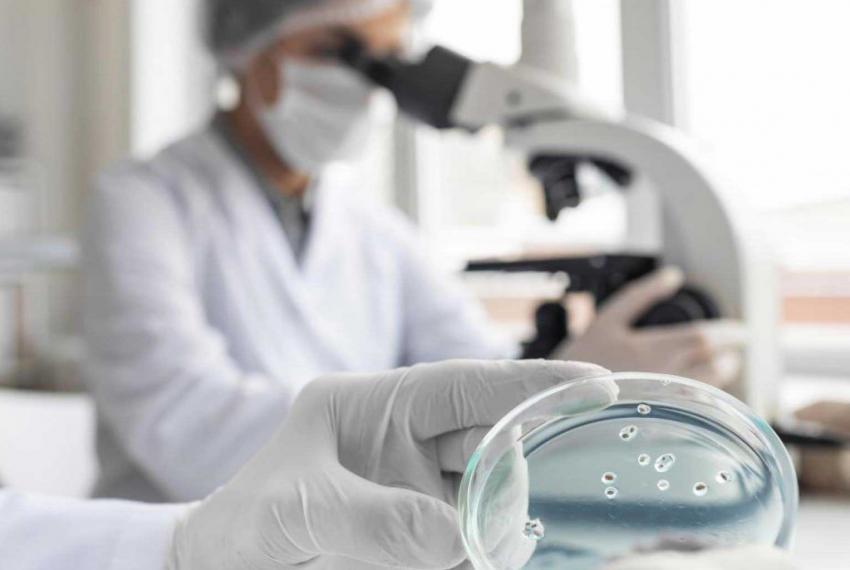

El Hospital de La Princesa recibe un premio de la Fundación Código Sepsis
COMUNIDAD DE MADRID, 11 de marzo de 2024
POR EL DESARROLLO E IMPLEMENTACIÓN REAL DEL"CÓDIGO SEPSIS PRINCESA"
El Hospital Universitario de La Princesa, centro público de la Comunidad de Madrid, ha sido premiado por la Fundación Código Sepsis en el marco de la quinta edición de los Premios Código Sepsis. Este galardón reconoce al grupo de profesionales que integran el 'Código Sepsis Princesa' por ser, desde el año 2015, una de las iniciativas organizativas en España que supuso la puesta a disposición de todos los especialistas del centro, de un conjunto de herramientas clínicas, organizativas, analíticas y microbiológicas, que sumadas a una intensa formación han ido mejorando notablemente la atención a los pacientes con Sepsis.
La Sepsis es una respuesta anómala del organismo a una infección bacteriana que puede provocar el fallo de uno o más órganos vitales, poniendo en peligro la vida del paciente. Esta patología afecta en España a 50.000 personas cada año de la cuales mueren 17.000, una cifra 13 veces superior a los fallecidos por accidentes de tráfico. Al igual que el Infarto de Miocardio o el Ictus, la Sepsis es una afección tiempo dependiente. Cada hora de retraso en la correcta administración de antibióticos se asocia a una disminución de la supervivencia del paciente, así como a un aumento de las posibles secuelas.
El "Código Sepsis Princesa" nace en el año 2015, siguiendo las indicaciones de un Código Sepsis Nacional el cual estaba avalado por 15 sociedadades científicas. De esta forma un grupo de profesionales del Hospital Universitario de La Princesa de los servicios de Urgencias, Medicina Interna, Microbiología Anestesiología y Reanimación Cirugía General y Digestivo así como personal de enfermería con el apoyo de la dirección del centro, decidieron abordar la creación de un protocolo propio que ha ido creciendo en implicación del resto de los servicios y aplicación de diferentes medidas. En sucesivos años, y coordinado por la Consejería de Sanidad de la Comunidad de Madrid, el Código Sepsis se fue extendiendo al resto de los hospitales públicos.
Reducción del tiempo del diagnóstico de Sepsis
Algunos ejemplos de las medidas realizadas dentro del "Código Sepsis Princesa" fueron la implementación en el sistema de información clínica del hospital de una alerta informática de Código Sepsis, que implica que todos los profesionales que van a atender a ese paciente conocen desde el primer momento que tiene máxima prioridad de atención por su patología. Avanzando en esa misma línea, el servicio de Microbiología incorporó, por primera vez en Europa, una nueva herramienta diagnóstica que ayuda a cumplir con uno de los principales objetivos de este protocolo: la reducción del tiempo de respuesta en la adecuación del tratamiento antibiótico ante un posible caso de Sepsis.
Los casi diez años de intensa labor del grupo "Código Sepsis Princesa" ha merecido el reconocimiento en forma de premio por parte de la Fundación Código Sepsis, cuya entrega tuvo lugar en la apertura del 7º Encuentro Internacional del Código Sepsis celebrado en Madrid el pasado 5 de marzo. El galardón lo recogió Rosa Méndez Fernández, anestesióloga del servicio de Anestesia y Reanimación del Hospital de La Princesa y miembro fundadora del grupo "Código Sepsis Princesa". Méndez estuvo acompañada por el director gerente José Julián Díaz Melguizo, la directora médica Gloria Torralbo Caballero y la directora de enfermería Pilar Prieto Alaguero.
Investigaciones de relevancia en torno a la Sepsis
Del mismo modo, el trabajo llevado a cabo en torno a la Sepsis en el centro madrileño, se ha traducido en investigaciones de relevancia como el último estudio con el título “Utilidad de los niveles de procalcitonina para predecir la orientación microbiológica en pacientes con Sepsis”, publicado en la revista Journal of Personalized Medecine por el grupo multidisplinar de profesionales del Hospital de La Princesa relacionados con esta patología en diferentes especialidades (Análisis Clínicos, Microbiología, Anestesia, Urgencias, Cirugía General y Aparato Digestivo, y Medicina Preventiva).
El principal objetivo del estudio ha sido verificar si los niveles de Procalcitonina (PCT) podrían orientar a los especialistas para determinar el tipo de bacteria que causa la Sepsis e identificar los parámetros específicos en la primera prueba de laboratorio. Todo ello, con la finalidad de ofrecer la máxima prioridad en la atención temprana de esta patología. La PCT es una prohormona muy sensible y específica de la infección bacteriana que proporciona información sobre el riesgo de que un paciente tenga una infección.
El estudio se realizó con 371 pacientes diagnosticados con Sepsis o Shock Séptico, con edades comprendidas entre los 15 y 71 años, siendo los resultados del mismo muy esperanzadores ya que los niveles de procalcitonina (PCT) encontrados han sido un buen indicativo para la confirmación del pronóstico de Sepsis. Este nivel diagnóstico se ha fijado en 3,6 ng/ml (nanogramos por mililitro).